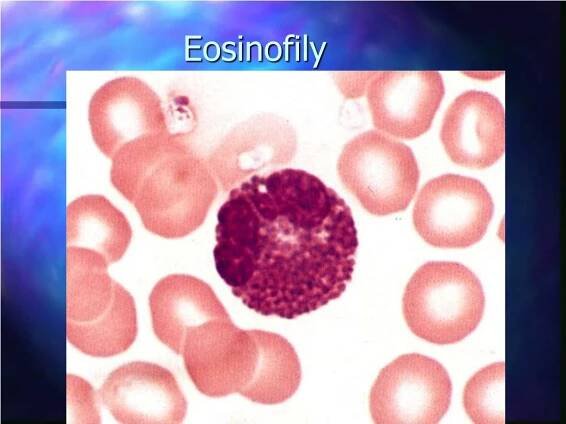

Eosinofily - eosinofilní granulocyty - jsou buňky, které patří do rodiny bílých krvinek, leukocytů. Eosinofily tak tvoří společně s ostatními bílými krvinkami imunitní systém člověka. Samotné eosinofily jsou zodpovědné zejména za boj proti parazitům, kteří napadli naše tělo...
Eosinofilní granulocyt – Wikipedie
Eosinofilní granulocyty, nebo také eozinofily, jsou buňky imunitního systému patřící do skupiny granulocytů. Mají charakteristickou morfologii, kdy jsou v cytoplasmě patrné četné granule a velké dvoulaločnaté jádro [1 ]. Název získaly podle…
eozinofily | NZIP
Eozinofily jsou buňky imunitního systému, které se řadí mezi bílé krvinky. Eozinofily hrají významnou roli v průběhu alergických reakcí (konkrétně při jejich ...
Eosinofily - Katalog laboratorních metod | Nemocnice Privamed
Eozinofilie (zvýšení): alergická onemocnění, dermatitidy, tumory, parazitární onemocnění, gastrointestinální onemocnění, virové nemoci, hypereozinofilní syndrom
Eosinopénie
Eozinofilní granulocyty (eozinofily) jsou bílé krvinky, které se řadí mezi granulocyty (společně s neutrofily abazofily).
Suchý dráždivý kašel, snížené IgA a zvýšené eosinofily | Pro…
Dobry de, prosim vas mam problem s 5 rocnym synom. Pred 3 tyzdnami zacal syn sucho drazdivo kaslat,myslela som ze laryngitida co maval aj predtym, ale tento kasel mal tyzden a opakoval sa denne,z.
Eozinofil | Medicína, nemoci, studium na 1. LF UK
Eozinofily jsou podtypem leukocytů (přesněji řečeno patří mezi granulocyty). Za normálních v krevním obraze tvoří pouze 1-3% bílých krvinek. Eozinofily vznikají v kostní dřeni a následně se dostávají do krve a jednotlivých tkání.
odkazuje na služby nejen od Seznam.cz.
© 1996–2025 Seznam.cz, a.s.